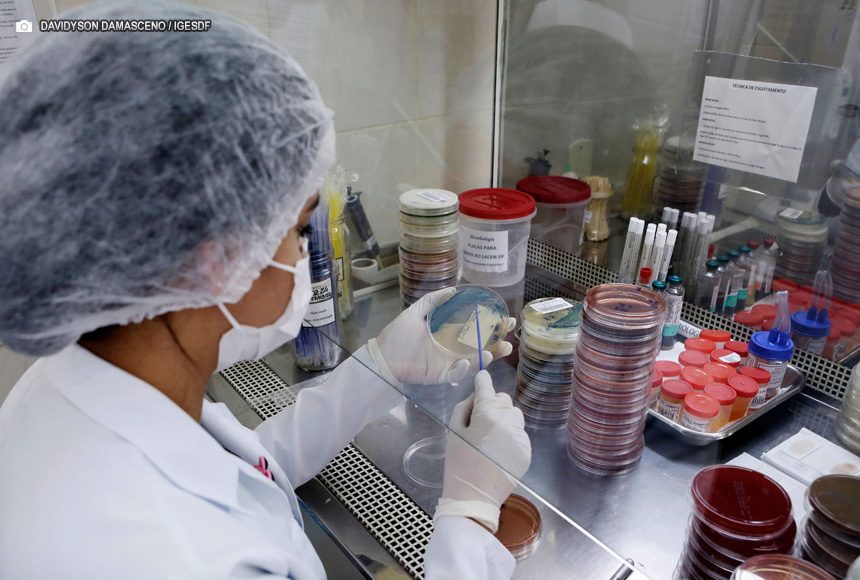

O Laboratório de Microbiologia do Hospital Regional de Santa Maria (HRSM) implementou uma nova técnica de testagem de antibióticos de última geração, o que possibilita dar maior celeridade ao tratamento de pacientes internados com bactérias multirresistentes.
Trata-se da implantação de métodos fenotípicos que contribuem de forma significativa no âmbito laboratorial para auxiliar e orientar a antibioticoterapia mais adequada, tanto quanto econômica, atuando na luta contra a resistência bacteriana. O método começou a ser realizado desde fevereiro. A técnica consiste em identificar mecanismos de resistência com testagem manual, em que é possível descobrir algumas resistências.
“No pós-covid percebemos o aumento de bactérias mais resistentes com o uso de múltiplas medicações. Por isso, com a testagem desses antibióticos de última geração, conseguimos dar mais opções de tratamentos para os médicos utilizarem”
Lucilene de Moraes
analista de laboratório
Segundo a Organização Mundial da Saúde (OMS), o aumento da resistência bacteriana é considerado um dos grandes problemas em saúde da atualidade. Por isso, a realização do antibiograma é de suma importância para nortear a equipe médica em relação à conduta terapêutica, contribuindo para o uso racional de antibióticos, minimizando falhas e aumentando a sobrevida do paciente, assim como, ajuda a mapear por meio dos fenótipos os perfis predominantes em cada comunidade ou unidade hospitalar.
Atualmente, o antibiograma é realizado por diferentes equipamentos de automação e técnicas manuais que detectam mecanismos de resistência, que por sua vez, confirmam os resultados apresentados pela automação.
“Através da técnica, conseguimos detectar e identificar bactérias que são resistentes a determinados farmacológicos e antibióticos. Os perfis não esperados são analisados e testados aqui para ajudar na rapidez do tratamento, pois identificamos quais são os melhores medicamentos para uso e fazemos o perfil epidemiológico na unidade”, explica o técnico de laboratório, Marlon Neris.
Com a implementação da técnica no próprio Laboratório de Microbiologia, o HRSM ganha vários benefícios, como o maior giro de leitos, a concentração inibitória mínima (MIC), que é tratar o paciente com uma dose menor para a bactéria, evitando administrar altas dosagens de antibióticos.
“Além disso, no pós-covid percebemos o aumento de bactérias mais resistentes com o uso de múltiplas medicações. Por isso, com a testagem desses antibióticos de última geração, conseguimos dar mais opções de tratamentos para os médicos utilizarem”, destaca a analista de laboratório Lucilene de Moraes.
Hoje, a testagem feita no Laboratório de Microbiologia permite que os antibióticos sejam testados de maneira mais rápida. “Agora, mandamos para o Lacen apenas os casos em que detectamos mais de uma resistência, para que lá seja feita a testagem de genes de bactérias”, informa o analista de laboratório Lucas Lemes.
A equipe do Laboratório de Microbiologia trabalha em conjunto com o Núcleo de Controle de Infecção Hospitalar (NCIH) na utilização dos novos antibióticos testados pela nova técnica. Os medicamentos são utilizados em pacientes internados na Unidade de Terapia Intensiva (UTI).